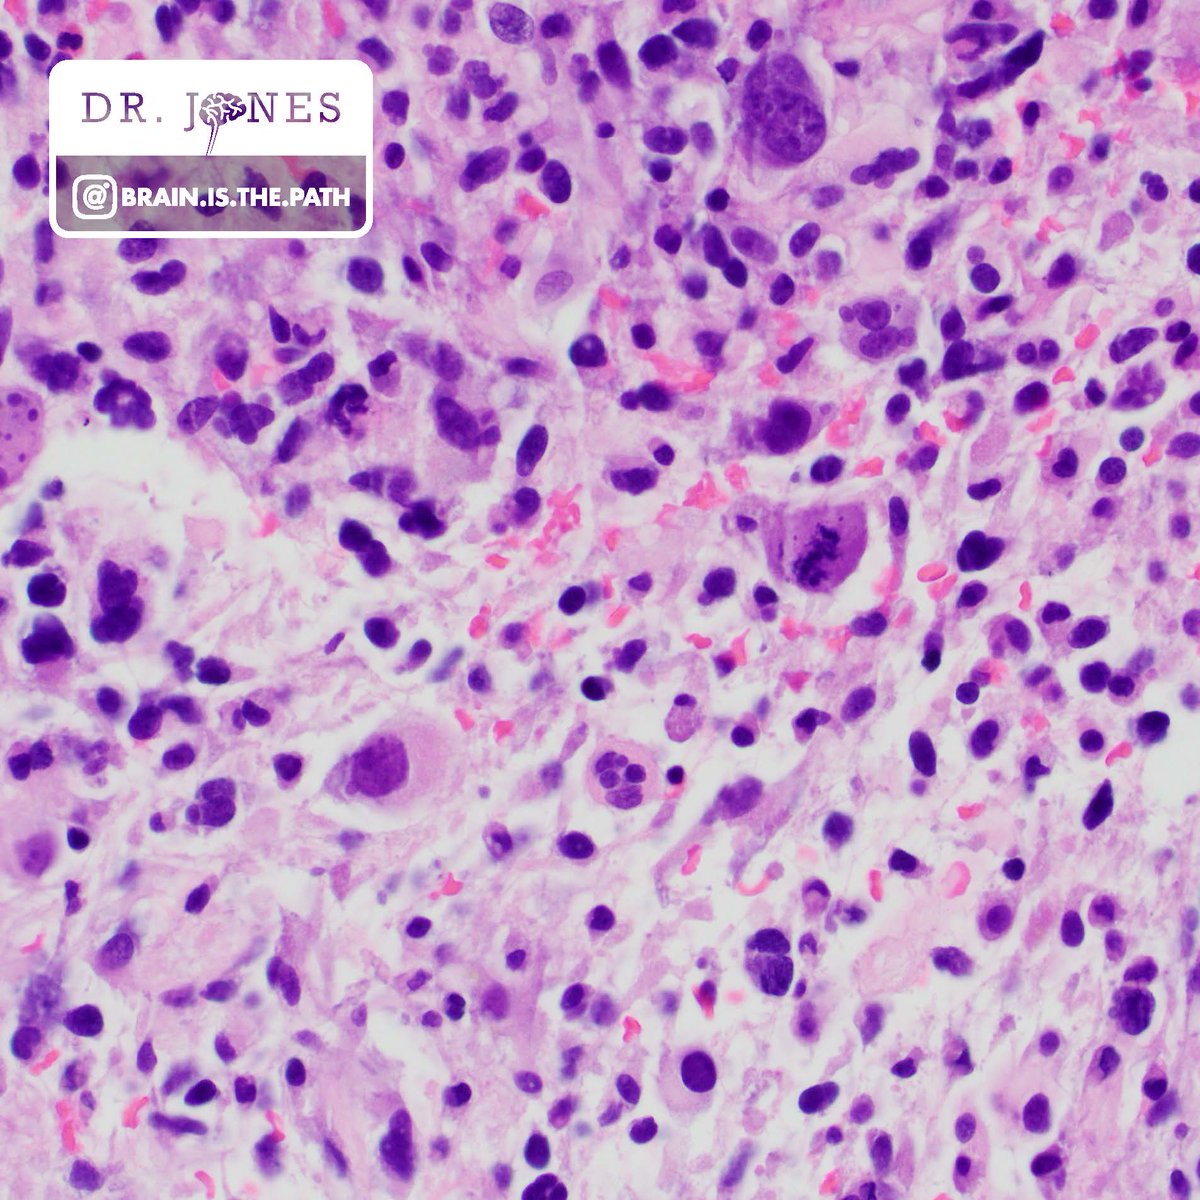
BrainIsThePath's tweet image. Let's work through a case together! Young adult with hemispheric brain mass with post-contrast enhancement. 
1. What is your histologic diagnosis
2. What IHC and/or molecular tests should we consider when we see this specific histopathology?
#neuropath @UIPathology

Karra Jones, MD, PhD
@BrainIsThePath
Neuropathologist @DukePathDept #neuropath | Duke Neuropathology Fellowship Program Director | @neuropathology fan girl | Tweets/RT for education only
You might like
Let's work through a case together! Young adult with hemispheric brain mass with post-contrast enhancement. 1. What is your histologic diagnosis 2. What IHC and/or molecular tests should we consider when we see this specific histopathology? #neuropath @UIPathology

Thinking about where to go for residency? Come to Duke’s online First Look Event on Wed., Aug. 28th, 7-8:30 p.m. ET & talk to program leaders, faculty, & residents. ALL med students welcome. Register here duke.is/Duke-First-Loo… #PathologyResident @dukegme

Join @neuropathology and @AMPath for our very exciting new course on Molecular Neuropathology! Monthly virtual lectures and in-person component at #2025AANP meeting. Register and boost your brain tumor molecular skills! neuropath.org/molecular-neur… FREE for trainees!

What a fun day at #neuropath2024 #aanp100! @DukePathDept represents with fellow @GChamberlinMD's presentation on meningiomas and future fellow @Levi_Endelman's poster. Busy day and to end it an exciting DSS! Yesterday @DrVanessaSmith rocked her presentation with @neurogiselle


Amazing talks on the history (Marta Margeta @UCSFPath) and future (Cherry Ho @JHUPath) of neuromuscular pathology at the #neuropath2024 meeting! 👏👏



🚨 The FDA's proposed rule on #LDTs (Laboratory Developed Tests) could drastically impact patient care by limiting access to essential diagnostic tests! Timely editorial by Dr. Genzen and Dr. Moser in @LabMedjournal #HealthcareReform #Pathology #LDTs" bit.ly/4bZtoPs…

Congrats to Dr. Vanessa Smith for her new faculty position at @UVA practicing molecular genetic pathology and neuropathology! She starts in August. She also recently gave a brain autopsy talk for AANP Teaching rounds. #pathology @dukemedschool pathology.duke.edu/news/dr-vaness…

Thrilled to be in Irvine with an amazing array of neuromuscular neurologists and neuropathologists at the @UCIMedSchool UCI Neuromuscular Pathology Colloquium today and the full Neuromuscular Colloquium tomorrow. I look forward to this every year!

Tremendous new resource by Dr. Bob Schmidt @wusm_pathology, a detailed online atlas of neuropathology! Check it out here neuropathologyatlas.wustl.edu It's a true labor of love by a legendary neuropathologist! #pathology #neuropath #pathtwitter
Join us Wednesday, April 24th for the next AANP Teaching Rounds session with @DrVanessaSmith presenting An Introduction to the Brain Autopsy Follow the link below for more information and to register. neuropath.org/teaching-rounds

PATHOLOGISTS are CLINICIANS: dont let anybody tell you otherwise!!! #pathtwitter repost please
I enjoyed showing some difficult #musclepath cases for @neuropathology Teaching Rounds today. Thanks to everyone for joining in! For those that couldn't make it, the Teaching Rounds sessions are all available via the @neuropathology YouTube channel.
Happening NOW!! Come join AANP teaching rounds with Dr. Jones, on case-based differential diagnosis of muscle pathology entities. @neuropathology @BrainIsThePath
We are excited for you all to join us as Blue Devils! Congratulations! 🎉
Join us in welcoming our newest #DukeMed #Pathology PGY-1’s on this Match Day! We look forward to having these six accomplished individuals join our Residency Program in July. #MatchDay2024 @DukeMedSchool duke.is/g/66ns

Had a great time talking about updates in #myositis pathologic diagnosis across town at @UNCMedCenter Rheumatology Grand Rounds! Strengthening our neuromuscular power in the Southeast together. And doesn't hurt that Spring has sprung on the UNC campus. 🌷


Join experts in #neuropath for a great learning session thanks to @TheUSCAP and @neuropathology!
We hope you will join us in our AANP/USCAP neuropathology update course! my.uscap.org/app/program/cB…

It was wonderful hosting the AANP @neuropathology Education Committee meeting here at Duke (and virtually) and having such strong brain power all in one place. We have some exciting projects ongoing and new ones in the works for #neuropathology!!

We have 1 opening for a 2025-26 Surgical Pathology Fellowship @DukeMedSchool. Fellows choose 2 subspecialty areas with potential for independent sign-out experience. Visit our fellowship page for details & contact us about this great opportunity. bit.ly/3T65cUF

Friendly reminder now that the Super Bowl and Valentine’s Day are behind us - your brain could use a glass of water.
Ok @Sara_Jiang, you can send me as many CSF cytology consults as you want!! The cutest. 😍

Join us Monday, January 22nd for the next AANP Teaching Rounds session with J. Stephen Nix, MD. Follow the link below for more information and to register. neuropath.org/teaching-rounds

Wonderful working with the awesome REDOX team @uiowa to move forward treatment options for our #braintumor patients!
Study by Petronek et al shows that pharmacological ascorbate plus #temozolomide and #radiotherapy significantly enhances GBM survival They also find that T2*-based MRI is a biomarker for clinical outcomes. bit.ly/412nsAW @BrainIsThePath @buettner_garry

United States Trends
- 1. Indiana 162 B posts
- 2. Oregon 145 B posts
- 3. #JennieRulesGDA 62,1 B posts
- 4. QUEEN JENNIE HAS ARRIVED 51,7 B posts
- 5. Mendoza 52,7 B posts
- 6. Giannis 14,1 B posts
- 7. Whale - Buy 4.897 posts
- 8. Jabari 3.872 posts
- 9. Cignetti 27,5 B posts
- 10. 2019 LSU 4.274 posts
- 11. #DigitalBlackoutIran 748 B posts
- 12. 5m TXs 2.202 posts
- 13. #IranRevolution2026 257 B posts
- 14. Dan Lanning 9.374 posts
- 15. 10m TXs N/A
- 16. Hamas 138 B posts
- 17. Moore 47,3 B posts
- 18. #iufb 8.089 posts
- 19. Konvy 5.088 posts
- 20. #DragRace 10,5 B posts
You might like
-
 University of Iowa Pathology
University of Iowa Pathology
@UIPathology -
 Maria Martinez-Lage, MD (she/her/ella) 🏳️🌈
Maria Martinez-Lage, MD (she/her/ella) 🏳️🌈
@mlage -
 Jared T. Ahrendsen MD, PhD (AP/NP/FP)
Jared T. Ahrendsen MD, PhD (AP/NP/FP)
@JaredAhrendsen -
 Michael Arnold, MD, PhD
Michael Arnold, MD, PhD
@MArnold_PedPath -
 Jennifer Moreira-Dinzey
Jennifer Moreira-Dinzey
@JenyaMD -
 Diane Brackett, MD
Diane Brackett, MD
@dgbrackett -
 Sarah Glogowski, DO
Sarah Glogowski, DO
@sarah_glogowski -
 Maryam Pezhouh, MD, MS
Maryam Pezhouh, MD, MS
@pezhouh -
 Mireille Bitar, M.D.
Mireille Bitar, M.D.
@bitar_mireille -
 Sam Khader, MD
Sam Khader, MD
@SamKhader -
 Prasu M
Prasu M
@PM_path -
 Raghavendra Pillappa
Raghavendra Pillappa
@raghupillappa -
 Fausto Rodriguez
Fausto Rodriguez
@FRodriguezNP -
 Kenneth Tang
Kenneth Tang
@drkennethtang -
 Miguel A. Guzman
Miguel A. Guzman
@miguelguzmanmd
Something went wrong.
Something went wrong.












































































































































